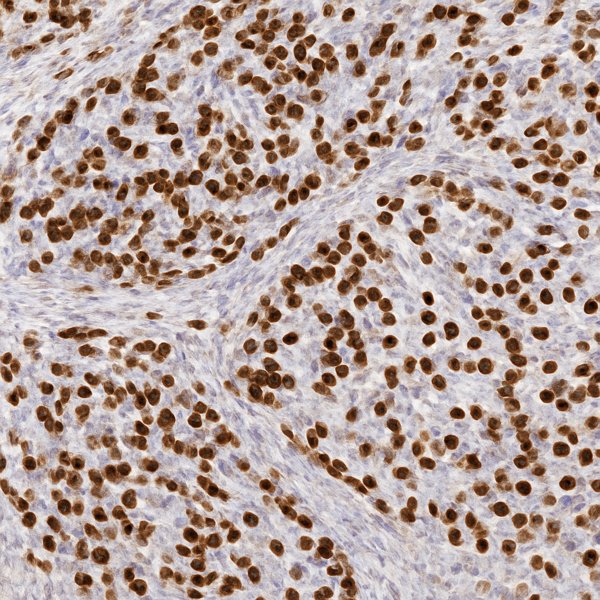

MSH6 Antibody (Immunohistochemistry)
The MSH6 Antibody is a key marker in diagnosis of colorectal cancer and related genetic disorders.
MSH6 is a protein involved in the Mismatch Repair (MMR) pathway, responsible for fixing replication errors in DNA.
This antibody is critical for detecting microsatellite instability (MSI) and evaluating MMR deficiency in tumors, especially in Hereditary Nonpolyposis Colorectal Cancer (HNPCC).
MSH6 is used in combination with other markers such as MSH2, MLH1, and PMS2 to identify mutations in the MMR pathway and assist in personalized treatment plans.
🔬 Features and Benefits MSH6 Antibody
-
Key marker for diagnosing colorectal cancer and genetic MMR disorders
-
Distinct brown nuclear staining
-
Helps identify MMR mutations and cancer susceptibility
-
Compatible with standard IHC protocols
-
Excellent stability: 18-month shelf life at 2–8 °C
💡 Diagnostic Applications
-
Detection of colorectal cancer and microsatellite instability
-
Genetic analysis of MMR-related tumors
-
Research on Hereditary Nonpolyposis Colorectal Cancer (HNPCC)
-
Identifying mutations in the MMR pathway
🌐 Fardad Azma Rad Co.
Fardad Azma Rad Co., the exclusive representative of Talent Biomedical in Iran, offers high-quality immunohistochemistry antibodies, including MSH6.
With a focus on scientific precision, diagnostic reliability, and international standards, Fardad Azma Rad supports pathology laboratories and molecular diagnostic centers throughout Iran.
There are no reviews yet.